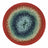

Schjeepjes - Cotton Whirl
Schjeepjes - Cotton Whirl - 701 Grape Jam är tillfälligt slut och kommer att skickas så snart den är i lager.
Vanligtvis redo inom 24 timmar
Scheepjes Cotton Whirl är ett färgskiftande garn i 100% ekologisk bomull. Garnet är mjukt och svalt där varje kaka innehåller 1000 meter, så du har långa flödande färgskiftningar. Det här garnet är utmärkt för sjalar, scarfs, filtar, heminredning och sommarkläder.
- Material: 100% ekologisk bomull (GOTS-certifierad)
- Vägledande stickfasthet: 25 maskor x 44 varv på 3,5 mm
- Rekommenderade stickor/virknål: 2,5 – 3,5 mm.
- Vikt / längd: ca 226 gram = 1000 meter.
- Arbetet kan tvättas i maskin på max 30°C
Om färgåtergivelse
Om färgåtergivelse
Vi gör alltid vårt yttersta för att produktbilderna ska återge färgerna korrekt. Skärmar visar dock färger olika, några kan visa dem djupare och starkare medan andra ljusare. Vi kan därför inte garantera att bilderna visar garnets exakta färg. Du kan alltid mejla oss på hej@lillagarnbutiken.se om du vill se fler bilder.
Tvätta och vårda
Tvätta och vårda
Färdiga plagg kan tvättas i maskin på ett fintvättsprogram. Max 30 grader och låga varvtal. Tvättas separat.
Låt plagget torka plant, gärna på en handduk. Plagget ska inte torkas i direkt sol, det kan utan problem vara i sol när det är torrt.
Schjeepjes - Cotton Whirl - 701 Grape Jam är tillfälligt slut och kommer att skickas så snart den är i lager.